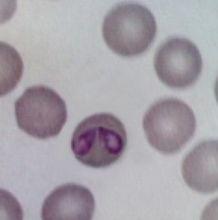
焦蟲

焦蟲
焦蟲 焦蟲相關圖片
焦蟲相關圖片焦蟲
piroplasmid
焦蟲綱(Piroplasmea)原生動物。雖不典型,但現一般把它與其他孢子蟲類群歸屬在一起。一些種類的焦蟲能引起牛羊焦蟲病。
焦蟲
焦蟲簡介
牛焦蟲病是由蜱為媒介而傳播的一種蟲媒傳染病。焦蟲寄生於黃牛、水牛和奶牛的紅細胞內,主要臨床症狀是高熱貧血或黃疸,反芻停止,泌乳停止,食慾減退,消瘦嚴重者則造成死亡。該病是由焦蟲在蜱體內繁殖,牛、羊放牧時蜱叮咬而感染的。此病以散發和地方流行為主,多發生於夏秋季節,以7—9月份為發病高峰期。有病區當地牛發病率較低,死亡率約為40%;由無病區運進有病區的牛發病率高,死亡率可達60%—92%。
牛巴貝西焦蟲病和牛環形泰勒焦蟲病
引起牛焦蟲病的焦蟲可分為牛巴貝西焦蟲病和牛環形泰勒焦蟲病兩種。
(一)牛巴貝西焦蟲病該病潛伏期為9—15天,突然發病,體溫升高到40%以上,呈稽留熱。病牛精神萎靡,食慾減退或消失,反芻停止,呼吸和心跳增快,可視黏膜黃染,有點狀出血,初期拉稀,後期便秘,尿呈紅色乃至醬油色。紅細胞減少,血紅素指數下降,急性病例可在2—6天內死亡。輕症病畜幾天后體溫下降,恢復較慢。
 焦蟲
焦蟲(二)牛泰勒焦蟲病該病潛伏期14—20天,病初體表淋巴結腫痛,體溫升高到40.5—41.7℃,呈稽留熱,呼吸急促,心跳加快。精神萎頓,結膜潮紅。中期體表淋巴結顯著腫大,為正常的2—5倍。反芻停止,先便秘後腹瀉,糞中帶血絲。可視黏膜有出血斑點。步態蹣跚,起立困難。後期結膜蒼白,黃染,在眼瞼和尾部皮膚較薄的部位出現粟粒至扁豆大的深紅色出血斑點,病牛臥地不起,最後衰竭死亡。患病牛要及早治療,撲滅體表的蜱。良好的飼養管理和護理對愈後有良好的效果。
防治
治療
(1)貝尼爾,每公斤體重用3.5-3.8毫克,配成5%—7%溶液深部肌肉注射。輕症1次即可,必要時每天1次,連注2—3次。水牛對此藥較敏感,一般用藥1次較安全,連續使用,易出現毒性反應,甚至死亡;黃牛偶爾出現起臥不安、肌肉震顫等副作用,可很快消失。
(2)黃色素,每公斤體重3—4毫克,配成0.5%—1%溶液靜脈注射,症狀未減輕時,24小時後再注射1次。病牛在治療後的數日內須避免烈日照射。注射時,切忌將藥液漏到血管外。
(3)阿卡普林,每公斤體重用0.6—1毫克,配成5%溶液皮下注射。有時注射後數分鐘出現起臥不安,肌肉震顫,流涎、出汗、呼吸困難等副作用(孕牛可能流產),一般於1—4小時後自行消失。若不消失,可皮下注射阿托品,每公斤體重10毫克,能迅速解除副作用。
(4)咪唑苯脲,每公斤體重2毫克,配成10%溶液,分2次肌肉注射。
(5)在選用以上藥物治療的同時,還應該採用對症療法,才能收到更好的效果,如用維生素B12治療貧血,中等個體的牛1次皮下注射1—1.5毫升(80—120毫克),有條件的,可套用輸血療法,效果更好。
預防
(1)有蜱的地區應定期滅蜱,牛舍內1米以下的牆壁,要用殺蟲藥塗抹,殺滅殘留蜱。
(2)對牛體表的蜱要定期噴藥或藥浴,以便殺滅之。
(3)不要到有蜱的牧場放牧,對在不安全牧場放牧的牛群,於發病季節前,定期藥物預防,以防發病。

